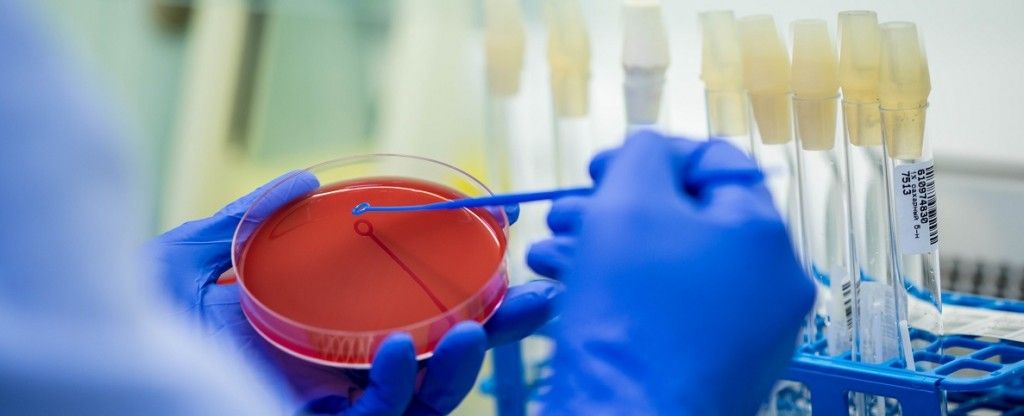

Дисбиоз что это чем он отличается от дисбактериоза
Под дисбактериозом понимают нарушение количественного соотношения микроорганизмов, населяющих кишечник. Условно-патогенные и патогенные организмы начинают преобладать над нормальной флорой, которая играет важную роль в жизнедеятельности организма.
Функции нормальной флоры:
- обеспечение кишечного газообмена;
- синтез витаминов и аминокислот;
- регулирование работы кишечных лимфоцитов;
- участие в регенерации клеток слизистой оболочки;
- активизация ферментов.
В норме размножение патогенных микроорганизмов сдерживается полезной флорой. Если большое количество полезных бактерий гибнет, они утрачивают способность контролировать рост патогенной флоры. Стрептококки, дрожжеподобные грибы, и другие патогенные бактерии активно размножаются, что может приводить к развитию различных заболеваний.
Дисбиоз кишечника может развиваться на фоне перенесенного заболевания, приема антибиотиков и ряда других лекарственных препаратов. В некоторых случаях нормальная флора восстанавливается самостоятельно, но может потребоваться и медикаментозное лечение. Игнорировать дисбиоз кишечника не стоит, так как он чреват развитием более серьезных проблем с ЖКТ, появлением аллергических реакций, повышением восприимчивости к инфекциям.

Немного истории
Дисбиоз кишечника не является самостоятельным заболеванием, но врачи уже более 100 лет назад пришли к выводу, что данное состояние может приводить к развитию различных патологических процессов, и потому нуждается в коррекции. В начале 20-го века И.И. Мечников положил начало изучению флоры кишечника и способов ее восстановления. Он первым начал лечить расстройства пищеварения у детей бифидобактериями. Термин дисбактериоз ввел в обращение в 20-х годах прошлого века ученый Нисле.
Факторы риска
Согласно статистике, около 90% людей сталкивались с проблемой дисбиоза. Это состояние широко распространено среди детей.. Дисбиоз часто игнорируют и обращаются к врачу только в тот момент, когда нарушение флоры кишечника привело к развитию какого-либо заболевания.
Вероятность развития дисбактериоза повышают:
- перенесенные вирусные заболевания;
- ослабленный иммунитет;
- заболевания ЖКТ;
- неблагоприятная экологическая обстановка;
- постоянные стрессы;
- прием гормональные препаратов, антибиотиков, химиотерапия.
На состоянии флоры кишечника негативно отражается курение, злоупотребление алкоголем. Также ее нарушение может быть вызвано нерациональным питанием (чрезмерное количество жирной, острой пищи, сладостей).
Развитие дисбиоза кишечника провоцируют следующие причины:
- резкая смена климата и привычного рациона во время путешествий;
- хирургические вмешательства, прием ряда лекарственных препаратов;
- дефицит ферментов, необходимых для переваривания пищи;
- неправильное питание, строгие диеты;
- заболевания ЖКТ (например, панкреатит, язва);
- кишечные инфекции;
- лактозная недостаточность;
- вирусные заболевания;
- нервные расстройства;
- паразитарные инвазии.
Это патологическое состояние диагностируют на основании клинической картины и лабораторных исследований. Симптомы зависят от индивидуальных особенностей организма и стадии дисбиоза.
Сразу после появления нарушений флоры клинические проявления отсутствуют или выражены очень слабо, так как компенсаторные возможности организма справляются с проблемой. По мере прогрессирования нарушений появляются характерные симптомы. Врач может заподозрить дисбиоз, если пациент жалуется на нарушения работы пищеварительной системы (диарею, запоры, вздутие, боли в животе), слабость, беспричинную раздражительность.
Если компенсаторные возможности организма снижены, дисбиоз способен привести к ухудшению общего состояния здоровья. Появляются головные боли, признаки интоксикации, тошнота, снижение аппетита, рвота, интенсивные болевые ощущения в животе. Человек теряет вес, возможно появление дерматитов, органических изменений органов ЖКТ.
Профилактика дисбиоза
Снизить вероятность развития дисбактериоза позволяет исключение из жизни факторов риска. В первую очередь это относится к соблюдению правильного питания. В повседневном рационе должно присутствовать достаточное количество кисломолочных продуктов. В них содержатся натуральные кисломолочные бактерии. Также необходимы продукты богатые клетчаткой, так как их употребление способствует созданию благоприятной среды для развития полезных микроорганизмов. Для нормальной работы кишечника необходимо также употребление достаточного количества овощей и фруктов.
После сильного стресса, перенесенных заболеваний, приема курса антибиотиков рекомендуется проконсультироваться с гастроэнтерологом. Он порекомендует профилактический курс пробиотиков.
Для грудных детей профилактикой дисбиоза является грудное вскармливание и введение прикорма только в соответствии с рекомендациями педиатра. Сдать анализы на дому или в офисе можно в любом медицинском центре Лабквест.
Дисбактериоз кишечника – это состояние, характеризующееся нарушением количественно и/или качественного состава местной микрофлоры. Изменение соотношения полезных и вредных микробов встречается у всех возрастных категорий. Дисбактериоз не является отдельным заболеванием. Под этим термином понимают любые изменения состава микрофлоры, вызванные внутренними или внешними факторами.
У взрослого человека дисбактериоз кишечника чаще всего возникает после приема антибиотиков, но может быть следствием многих заболеваний. Тактику лечения врач подбирает в зависимости от причины нарушений, симптомов и характера отклонений в анализах.

Чем отличается дисбактериоз от дисбиоза
Причины нарушений
Микрофлора здорового кишечника на 98% представлена полезными микробами. У взрослого человека вес этих обитателей составляет 2-3 кг.
К полезным бациллам относятся бифидо- , лактобактерии. Они обеспечивают процесс пищеварения, защищают слизистую кишечника от инфекций, аллергенов, стимулируют иммунитет, обеспечивают всасывание полезных веществ. Помимо полезных бактерий, микрофлора содержит условно-патогенные организмы: протей, стафилококки, клебсиеллу, дрожжеподобные грибы. В нормальных условиях они не приносят вред, напротив, помогают поддерживать биологические процессы. Оптимальные условия для размножения и активации патогенных качеств создаются, когда человек подвержен влиянию негативных факторов.
Причины дисбактериоза разнообразны. Нарушение баланса в кишечнике у взрослого человека происходит из-за внешних и внутренних провокаторов. Основные причины:

Бактерии живут не только в просвете кишечника, но и в слоях эпителия. Соотношение микроорганизмов, заселяющих углубления слизистой оболочки, имеет устойчивый состав. Полостная микрофлора постоянно меняется.
В период беременности нарушения микрофлоры вызывают изменения иммунологического и гормонального фона. Кишечные расстройства нередко провоцируют бактериальный дисбаланс половых органов. Если женщина вовремя сдает анализы, проблем не возникает. Врач назначает вагинальные свечи, дает рекомендации по поводу диеты. Коррекция кишечных расстройств осуществляется с помощью разрешенных препаратов.
Стадии развития заболевания
По характеру течения различают острую, затяжную и хроническую форму патологии. Нарушение баланса может затрагивать тонкий и толстый кишечник.
Дисбактериоз протекает в 4 стадии. Незначительное нарушение баланса при 1 степени патологии выражается в количественном изменении кишечных палочек. Бифидобактерии, ацидофилы в норме.
На 2 стадии снижается количественное и качественное значение кишечных палочек, незначительно увеличивается состав условно-патогенных микроорганизмов. Значение бифидобактерий, ацидофилов ниже нормы.
Третья стадия дисбактериоза характеризуется значительным уменьшением бифидобактерий в комбинации со снижением числа ацидофилов. В анализе кала высеивается кишечная палочка с вредными свойствами.
На 4 стадии наблюдается резкое снижение бифидобактерий либо полное их отсутствие. Количество кишечных палочек с типичными свойствами, ацидофилов уменьшается или равно нулю. В анализе обнаруживают патогенные дрожжи, шигеллы, сальмонеллы и др. вредные штаммы, не характерные для нормальной микрофлоры.
Симптомы
Признаки дисбактериоза всегда связаны с расстройствами пищеварения. Первые симптомы отклонения в составе микрофлоры:
- проблемы с опорожнением кишечника – жидкий стул чередуется с запором;
- изменение структуры каловых масс – начальная порция твердая, последующие отличаются жидкой консистенцией с остатками непереваренной пищи, слизи;
- скопление газов – в животе ощущаются переливы, вздутие, урчание;
- ложные позывы к дефекации.

Если причина дисбактериоза – хронические заболевания ЖКТ, у человека может появляться отрыжка, тошнота, рвота, боли под ребрами.
Затяжной дисбактериоз часто проявляется прыщами на лице, крапивницей, сыпью. Нестабильное опорожнение кишечника связано с нарушением всасывания питательных веществ, изменением pH-уровня кишечной среды. Из-за дефицита полезных микробов замедляется обмен желчных кислот, необходимых для нормального пищеварения. Газы абсорбируются не полностью, скапливаются в кишечнике. Это приводит к болезненному вздутию живота.
Активация гнилостных процессов проявляется тяжестью в брюшной полости, коликами, урчанием. Брожение возникает из-за распространения дрожжеподобных грибков, которые хорошо приживаются в кислой среде.
У женщин нарушение баланса бактерий может осложниться молочницей, вагинозом. Признаки дисбактериоза кишечника со временем дополняются:
- неприятным запахом изо рта;
- металлическим привкусом между приемами пищи;
- пищевой аллергией (чаще всего на молочные продукты).
На 3 и 4 стадиях дефицит полезных микробов приводит к разладам в работе органов и систем. В этом случае к основным симптомам присоединяются признаки, характерные для других заболеваний:
- одышка;
- боли в сердце;
- анемия;
- раздражительность;
- слабость;
- бессонница;
- потливость.
Такие проявления могут быть как причиной нарушения микрофлоры, так и его следствием.
У женщин и мужчин симптомы запущенного дисбактериоза кишечника всегда отражаются на внешности: бледнеет кожа, ломаются ногти, выпадают волосы, появляются заеды в уголках губ. По таким признакам у взрослого человека можно определить авитаминоз, вызванный плохой всасываемостью питательных веществ. Дисбактериоз кишечника может сопровождаться небольшим повышением температуры (до 37,2 градуса), снижением аппетита, непереносимостью белковых продуктов.
Диагностика
Задача лечащего врача – найти причину, которая спровоцировала нарушения микрофлоры. В зависимости от нее может потребоваться консультация врача-терапевта, гастроэнтеролога, инфекциониста, аллерголога.
Диагностика дисбактериоза включает:
- общий и/или биохимический анализ крови;
- копрограмму – изучение кала для оценки ферментативной способности, усвояемость пищи;
- исследование метаболической активности микрофлоры.
На первичном приеме врач изучает анамнез, проводит пальпацию живота. Поскольку симптомы дисбактериоза схожи с признаками заболеваний ЖКТ, для уточнения диагноза могут назначить фиброэзофагогастродуоденоскопию (ФГДС), ультразвуковое исследование брюшной полости.
Помимо анализов, в некоторых случаях проводят:
- молекулярные тесты путем полимерной цепной реакции;
- дыхательные тесты, чтобы оценить состояние тонкой кишки;
- колоноскопию – введение в прямую кишку зонда с оптическим прибором;
- анализ мочи на содержание индола, скатола.

Лабораторные исследования в совокупности позволяют определить количество бактерий, стадию дисбактериоза, а также выявить отдел пищеварительного тракта с изменениями микрофлоры.
Анализ кала показывает значение только тех микробов, которые попали в просвет кишечника, поэтому часть специалистов считает его малоинформативным.
Как лечить дисбактериоз у взрослых
Схему терапии врач подбирает исходя из результатов анализов. Комплексное лечение дисбактериоза назначают при распространении патогенных бактерий. Методы терапии различаются в зависимости от вида микроорганизмов, которых в кале обнаружено выше нормы.
- диету;
- препараты для устранения вредных микробов;
- живые бактерии для поддержки кишечной среды;
- растительные средства, улучшающие работу ЖКТ.
Особенности диеты
Корректировка питания – залог успешного лечения кишечника у детей и взрослых. При легкой степени дисбактериоза неприятные симптомы исчезают без применения лекарств, с помощью диеты. Если в анализах присутствуют патогенные микроорганизмы, особый режим питания сочетают с медикаментозным лечением.
Диета при дисбактериозе исключает блюда, вызывающие распространение патогенных микробов, раздражающие слизистую оболочку, повышающие кислотность желудочного сока. Из меню убирают:
- консервы;
- копчености;
- маринады;
- соусы;
- легкоусвояемые углеводы – сдобу, макароны из мягких сортов пшеницы;
- ржаной хлеб;
- наваристые бульоны;
- молоко;
- сырые овощи;
- острые специи;
- соки;
- вареные яйца (они обладают желчегонным действием);
- кофе;
- алкоголь;
- газированные напитки.

Ограничения в питании во многом зависят от характера стула. При склонности к поносам временно исключают продукты, усиливающие двигательную активность кишечника: растительные масла, грубую клетчатку (свежие фрукты, цельнозерновой хлеб, отруби, капусту, сухофрукты). Людям, склонным к запору, рекомендуют ограничить тонизирующие напитки, рис, крахмалистые овощи.
Есть нужно небольшими порциями, 4-5 раз в день. Напитки и воду пьют между приемами еды. Такая мера облегчает дискомфорт в кишечнике. Пищу лучше всего принимать в одно и то же время, чтобы наладить работу ЖКТ.
При легкой степени дисбактериоза без выявления патогенных бактерий, дрожжей рекомендуется употреблять кисломолочные продукты: свежий кефир, йогурт на живой закваске, сыворотку, Айран, Бифидок, Наринэ.
Для роста и размножения лакто- и бифидобактерий полезно есть:
- творог в запеченном виде;
- сыр нежирных сортов;
- овощные салаты из отварных овощей, заправленные сметаной;
- гречу;
- овсяные хлопья;
- рис;
- брокколи;
- тыкву;
- морковь;
- кабачки;
- кисели на основе черники, черной смородины, черемухи, айвы.
Медикаменты
Схема лечения включает 2 этапа: устранение патогенных микробов, заселение кишечника полезными бактериями. В период приема назначенных препаратов соблюдают подобранную врачом диету.
Длительность лечения дисбактериоза зависит от степени нарушения, а также причины, которая вызвала отклонения. Если в анализе не выявлено патогенных микробов, терапия включает только второй этап.
После длительного приема одной или нескольких групп антибиотиков назначают поддерживающее лечение препаратами, содержащие живые микрокультуры. Их подбирают в зависимости от симптоматики дисбактериоза.
Чтобы определить, какой препарат больше подойдет, врач оценивает pH-уровень кишечного содержимого. Этот показатель очень важен в подборе лекарств. Для защелачивания излишне кислой среды подойдет препарат Хилак форте, вода с лимоном. Несмотря на кислый вкус, эти средства в процессе пищеварения образуют щелочь.
Излишне щелочная среда может указывать на нарушения синтеза соляной кислоты в желудке. В этом случае назначают препараты и диету, направленную на закисление ЖКТ.
Лечение дисбактериоза начинают с устранения вредных микробов. Для этого могут назначить препараты из группы:
- Кишечные антисептики. Они действуют в полости кишечника, но при этом не всасываются его стенками. Выбор антисептика врач осуществляет исходя из вида патогенных бактерий, обнаруженных в анализе. Препараты из этой группы – Нифуроксазид, Энтерофурил, Стопдиар, Ципрофлоксацин, Офлоксацин, Альфа Нормикс.
- Противогрибковые средства – Ирунин, Пимафуцин, Нистатин, Дифлазон. Их сочетают с кишечными антисептиками в случаях, когда микрофлора заселена грибками (чаще всего дрожжами, кандидой) и патогенными бактериями.
- Антибактериальные препараты на основе Тетрациклина, Пенициллина и других средств широкого спектра действия. Лекарства назначают, если нарушение произошло из-за бактериальной инфекции, воспаления. Такое состояние сопровождается высокой температурой, диареей.
- Бактериофаги – это вирусы, которые при попадании в кишечник избирательно внедряются в бактерии на уровне ДНК. Это приводит к полному уничтожению нужного типа патогенных микробов. Бактериофаги – это специфическая группа лекарств с узких спектром действия, в отличие от антибиотиков, антисептиков. К примеру, стафилококковый дисбактериоз лечат препаратом Бактериофаг стафилококковый. Распространение кишечной палочки угнетает средство, уничтожающее только этот вид микробов. Бактериофаги для лечения дисбактериоза часто сочетают с антисептиком, чтобы повысить эффективность терапии.
- Энтеросорбенты – Полисорб, Смекта, Энтеросгель, белый уголь. Взрослым один из препаратов этой группы назначают вместе с антибиотиком, если нарушение микрофлоры вызвано инфекцией. Короткий курс сорбентов помогает избавиться от симптомов дисбактериоза путем выведения из организма биологически активных метаболитов, токсичных веществ.
- Растительные препараты с желчегонным действием – Хофитол, экстракт Артишока. Они помогают снять тяжесть в животе, метеоризм, тошноту. Курс лечения – 2-4 недели.

Чтобы заселить кишечник полезными бактериями, применяют средства, в составе которых есть высушенные, живые микробы или вещества, способствующие их распространению. Как правило, такие медикаменты принимают после лечения кишечными антисептиками, антибиотиками, противогрибковыми средствами.
Основные группы средств, которые используют в лечении дисбактериоза:
- Пробиотики. К данной группе относят Бифидумбактерин, Бифилиз, Ацилакт, Бактистатин. Нехватку лактобацилл компенсируют приемом пробиотиков марки Нормофлор, Аципол, Гастрофарм. При небольших отклонениях в составе кишечной микрофлоры лечить дисбактериоз можно одним из этих средств на протяжении 7-10 дней без применения других медикаментов.
- Пребиотики – это пища для полезных бактерий. Прием таких препаратов стимулирует рост микроорганизмов, отвечающих за правильную работу кишечника. Торговые марки – Эубикор, Дюфалак, Прелакс, Лактусан.
- Метабиотики – вещества, которые полезные микробы выделяют в результате жизнедеятельности, – ферменты, гормоны, витамины. Характерные особенности препаратов этой группы – они не погибают в кислой среде желудка, восстанавливают поврежденные участки слизистой, стимулируют защитные реакции организма. Их можно принимать одновременно с антибиотиками, чтобы избежать диареи. К метабиотикам относится Хилак форте, Актофлор-C.
- Синбиотики – это сочетание про- и пребиотика в одном препарате. Лечить дисбактериоз можно торговыми марками из этой группы средств – капсулы Максилак, Риофлора.
Коррекцию микрофлоры иногда сочетают с витаминотерапией (Декамевит, Мультитабс, Феррум лек, фолиевая кислота), иммуномодуляторами (настойка эхинацеи, Дибазол).
Народные методы
Для подавления грибка используют настои с корнем аира, листьями брусники, черной смородины. Уменьшить брожение, газообразование поможет ромашка, шиповник, календула. Для нормализации жидкого стула используют корень кровохлебки, щавеля, плоды черемухи, черники. Чтобы восстановить иммунитет после дисбактериоза, пьют отвар из крапивы, мать-и-мачехи, василька.

Помимо настоев и клизм из лекарственных растений, дискомфорт в кишечнике помогают устранить народные средства:
- Чеснок. Антибактериальные свойства этого овоща подавляют патогенную микрофлору. Для нормализации состояния 2 раза в день проглатывают зубчик чеснока. Эффект будет заметнее, если его не разжевывать.
- Вода с прополисным медом. Продукты пчеловодства обладают противовоспалительным, антимикробным действием, поэтому их часто применяют для нормализации кишечной микрофлоры. Чайную ложку прополисного меда растворяют в стакане теплой воды и пьют через 20 минут после еды. Курс терапии – 1 месяц.
Методы лечения дисбактериоза у взрослых отличаются в зависимости от вида патологии. Кишечные расстройства – это следствие многих заболеваний. Чтобы вылечить дисбактериоз, важно устранить его причину. Если принимать только лекарства для устранения симптомов, патогенная микрофлора восстановит свои свойства после окончания курса.
Информация на нашем сайте предоставлена квалифицированными врачами и носит исключительно ознакомительный характер. Не занимайтесь самолечением! Обязательно обратитесь к специалисту!

Гастроэнтеролог, профессор, доктор медицинских наук. Назначает диагностику и проводит лечение. Эксперт группы по изучению воспалительных заболеваний. Автор более 300 научных работ.

Под дисбактериозом в широком смысле подразумевают качественные и количественные изменения в составе нормальной микрофлоры кишечника, слизистых, кожи. В тяжелых случаях дисбактериоза нарушается не только состав бактерий, но и активно размножается грибковая флора, с которой бороться наиболее сложно. Поэтому современное название данного болезненного состояния звучит как дисбиоз, т.е. нарушение состава всей флоры.
Чаще всего приходится сталкиваться с дисбиозом кишечника. Он выражается в значительном увеличении количества микроорганизмов в тонкой кишке и в изменении состава микрофлоры в толстой кишке. Это бич нашего времени. Он может никак себя не проявлять, а может вызывать серьезные расстройства пищеварения (вздутие, понос, тошнота).


Выделяют также дисбактериоз:
Дисбиоз все чаще преследует и детское, и взрослое население. В его возникновении повинны многие факторы. Его проявления нарушают нормальное самочувствие человека, а борьба с ним - процесс очень непростой. Для лечения дисбактериоза официальная медицина часто назначает синтетические антибактериальные средства. Но что делать, если пить антибиотики и другие химические лекарства совсем не хочется?
Вам на помощь придет народная медицина. Ее рецепты просты, доступны и безопасны. О том, почему возникает это состояние, чем проявляется и, главное, как помочь преодолеть недуг средствами народной медицины, и пойдет речь.
КИШЕЧНЫЙ ДИСБИОЗ
В разной степени выраженности дисбиоз отмечается практически у всех больных с хроническими заболеваниями кишечника, а также при нерациональном питании и после приема антибактериальных лекарственных препаратов.
В норме в кишечнике имеется два вида микроорганизмов: постоянные (собственная нормальная микрофлора) и случайные. Постоянные микроорганизмы заселяются в кишечник в первые дни жизни ребенка в процессе прохождения родовых путей и с молоком матери. В течение первых 3-х дней жизни, когда еще не сформирован иммунитет у малыша, и формируется его нормальная микрофлора. Эти постоянные микроорганизмы присутствуют в кишечнике всегда. Общая масса всех микроорганизмов, колонизирующих органы и ткани человека, равняется 3-5 кг, что составляет около 5% от массы тела.
Нормальная микрофлора распределена неравномерно в организме человека, и более 60% общего количества микроорганизмов сосредоточено в желудочно-кишечном тракте.
Дисбиоз кишечника - это патологическое изменение качественного состава микрофлоры пищеварительного тракта, и это не клинический диагноз, а состояние, сопровождающее большинство заболеваний человека.
Важно не пропустить! Какие симптомы?
Понятие дисбиоза стало нынче модным, и порой этот синдром ставят чаще, чем он имеет место на самом деле. И в то же время пропустить начало его развития тоже легко, потому как проявления неспецифические.
Какие симптомы должны насторожить, что позволяет заподозрить нарушения микрофлоры кишечника?
В первую очередь, безусловно, возникнут нарушения со стороны ЖКТ (диспепсические явления):
- ✅ Изжога, отрыжка, тяжесть в животе, тошнота и даже рвота.
- ✅ Вздутие (метеоризм). В здоровом организме целлюлоза, которая входит в состав фруктов, овощей, бобовых, расщепляется в кишечнике с образованием свободного газа. Многие из микроорганизмов в числе нормальной флоры являются аэробами, то есть для их существования нужен газ, они его поглощают. При недостатке полезных бактерий, утилизирующих газ, наблюдается обильное, частое газовыделение. Это один из наиболее часто встречающихся симптомов дисбактериоза кишечника.
- ✅ Могут возникать болевые ощущения в животе вследствие патологических изменений в кишечнике, чаще воспалительного характера (колит, энтерит). Приходится лечить и возникший энтероколит, и заниматься нормализацией микрофлоры кишечника.
- ✅ Запоры или диарея, которые могут чередоваться.
- ✅ Заболевание часто проявляется субфебрильной температурой. Вследствие нарушения переваривания пищи и усвоения жизненно важных веществ (витаминов, минералов) страдает весь организм. Отсюда возникают такие признаки дисбиоза, как усталость, быстрая утомляемость, сухость кожи, трещины уголков губ.
- ✅ Кроме того, для больных дисбактериозом характерен астено-невротический синдром: больные апатичны, часто жалуются на головную боль, общую слабость, быструю утомляемость, ухудшение сна. Их трудоспособность снижается. Появляются признаки пищевой аллергии, часто в виде крапивницы, высыпаний на коже и атопического дерматита.
Для постановки диагноза при столь неспецифичных жалобах больного врач анализирует симптомы, а также проводит ряд лабораторных исследаваний. Производится анализ кала, который может показать недостаточность переваривающей функции кишечника (в кале непереваренные кусочки пищи, зерна крахмала, жирные кислоты). Но наиболее точно диатез подтверждает бактериологический посев кала, который показывает, какие возбудители преобладают и к каким антибактериальным средствам они чувствительны. Единственный недостаток этого метода -длительное время проведения исследований, необходимое для выращивания культуры микробов. Весь процесс занимает 7-10 дней.
Роль нормальной микрофлоры в здоровье
Сейчас уже широко известно, что для здоровья кишечника необходима его здоровая собственная микрофлора. Но только ли состояние кишечника определяют эти полезные микроорганизмы?
Наш организм тесно связан с окружающей средой, но и он, в свою очередь, является средой обитания огромного количества микроорганизмов.
Особенно густонаселенным является кишечник. Это микромир в нашем организме, без которого человек существовать не может. Если погибает вся полезная флора, то человек умирает.
Процесс взаимодействия нормальной микрофлоры ЖКТ и организма человека - это сложный многоуровневый процесс. В зависимости от условий различные представители кишечной микрофлоры способны оказывать как положительное, так и отрицательное действие на организм человека. Считается, что абсолютно положительным действием обладают микроорганизмы рода бифидобактерий, лактобацилл и эубактерий.
Остальные представители нормальной микрофлоры могут приносить пользу или вред в зависимости от их количества. Такие микроорганизмы называются условно-патогенными. Если их мало, то организм не страдает, а если возникли условия, позволяющие им активно размножаться, то они резко растут в своей численности и нарушают пищеварение. Если говорить о составе микрофлоры кишечника, то 90-98% приходится на бифидобактерии, 1-9% представлены лактобакгериями, кишечной палочкой и энтерококками, и только 1% занимает патогенная флора.
Роль нормальной микрофлоры кишечника трудно переоценить. Но в первую очередь она способствует образованию биологически активной пленки, которая защищает слизистую оболочку от воздействия патогенных микроорганизмов.
Случайные же микроорганизмы проходят через кишечник транзитом, не нанося вреда. Но при определенных условиях они задерживаются в кишечнике, подавляя развитие собственной полезной микрофлоры, активно размножаясь и вызывая дисбактериоз. В результате нарушается структура слизистой оболочки кишки, что приводит к различным заболеваниям самого ЖКТ и всего организма. Частым следствием дисбиоза кишечника являются заболевания кожи.
Микрофлора - это важнейшая часть адаптационного механизма, она специфически регулирует обмен веществ и функции организма.
Основные функции кишечной микрофлоры:
- ✅ • участие в водно-солевом обмене и поддержании рН.
- ✅ • участие в метаболизме углеводов, белков, липидов и других соединений;
- ✅ • участие в рециркуляции желчных кислот, гормонов и других веществ;
- ✅ • продукция биологически активных соединений (летучих жирных кислот, витаминов, гормонов, токсинов, антибиотиков и др.);
- ✅ • это составляющая часть иммунитeтa, защита от патогенных микроорганизмов;
- ✅ • нейтрализация токсинов, поступающих извне и образующихся внутри организма;
- ✅ • защита от мутаций клеток;
- ✅ • регуляция газового состава кишечника;
- ✅ • хранилище микробных и хромосомных генов (важно для поддержания стабильных микробных сообществ в различных человеческих популяциях).
Особо следует сказать о тесном взаимодействии микрофлоры с иммунной системой. Сила и характер иммунного ответа организма будут в значительной степени зависеть от состояния кишечного биоценоза.
Учитывая такое разностороннее участие флоры кишечника в жизнедеятельности организма, надо всячески беречь свою микрофлору, правильно питаясь и избегая факторов, повреждающих ее.
Кто виноват и что делать?
Дисбактериоз причиняет много неприятностей, поэтому желание избежать этого состояния естественно. Что же может привести к возникновению дисбиоза кишечника? Как сохранить полезную микрофлору?
Различные неблагоприятные факторы окружающей среды и самого организма способны вызывать изменения в микрофлоре по типу дисбиоза.
Дисбиозы могут возникать при воздействии на организм человека широкого круга факторов риска: различных заболеваний, стрессов, погрешностей в питании, а также в результате применения антибиотиков, лучевой терапии и других неоднозначных для организма методов лечения.
Современные исследования свидетельствуют, что нарушения кишечной микрофлоры встречаются у 90-100% больных с заболеваниями внутренних органов. К ним относятся заболевания органов пищеварения, сердечно-сосудистые, обменные заболевания, онкопатологические процессы, аллергические и аутоиммунные заболевания и многие другие.
В свою очередь эти изменения, достигнув определенного уровня, ухудшают клиническое течение основного заболевания. В связи с этим поддерживать состояние нормальной микрофлоры следует при развитии любого заболевания, и особенно при применении агрессивных методов лечения типа антибиотикотерапии, химио- и лучевой терапии. К серьезному дисбиозу может также привести стресс, как острый, так и хронический.

Мероприятия по поддержанию нашей нормальной микрофлоры следует проводить регулярно, а особенно при воздействии указанных выше факторов. Это должно выражаться в правильном питании, а также применении дополнительных мер по восстановлению полезной микрофлоры.
Можно ли вылечить дисбиоз?
Можно ли вылечить дисбиоз и что для этого требуется? Под силу ли эта задача народной медицине или без аптечных препаратов не обойтись?
Для начала нужно установить точный диагноз. Поэтому при любых нарушениях деятельности кишечника следует сразу обратиться к врачу.
Симптомы дисбиоза, как уже говорилось, неспецифичны, похожие проявления могут иметь другие заболевания. Чем раньше будет поставлен диагноз, тем больше шансов восстановить нормальный состав микрофлоры в кишечнике.
Поэтому начинать надо с лечения основных заболеваний, и только как процесс параллельный необходимо оказывать специфическое воздействие на кишечную микрофлору.
Под специфическим воздействием подразумевается использование лекарственных препаратов, биологически активных добавок к пище, трав, продуктов питания и других средств, оказывающих непосредственмое влияние на представителей кишечной микрофлоры.
Основными направлениями воздействия будут следующие:

- ✅ Торможение роста и размножения болезнетворных и условно-патогенных микроорганизмов.
- ✅ Создание нужной среды и оптимальных условий для развития нормальной микрофлоры.
- ✅ Укрепление иммунитета.
- ✅ Прямое влияние на состояние и функции организма с целью устранения негативных симптомов и последствий дисбиоза.
Народные средства при правильном применении успешно справляются с проблемой дисбиоза и способны охватить все указанные лечебные направления.

Дисбактериоз кишечника у взрослых: причины, симптомы, лечение дисбактериоза
Читайте также:


